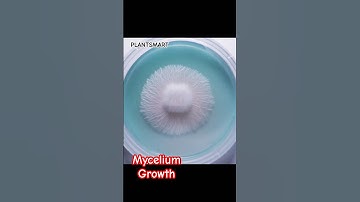
Mycelium Growth Study #mycelium #growth #study #fungi #fungus

⬇ DOWNLOAD NOW
Kalau muncul iklan pop-up, tutup lalu klik tombol kembali
Download lagu Mycelium Computation Awakens secara gratis hanya untuk keperluan promosi. Dukung artis favorit kamu dengan membeli musik original di iTunes atau platform resmi lainnya.
Mycelium Growth Study #mycelium #growth #study #fungi #fungus
Mycelium Growth Study #mycelium #growth #study #fungi #fungus
 They turned mushrooms into a COMPUTER
They turned mushrooms into a COMPUTER
 Mycelium Flow
Mycelium Flow
 Mycelium and advanced super computers
Mycelium and advanced super computers
 The worlds deadliest #mushroom talking #mycology #mushroommusic #fungi #nature
The worlds deadliest #mushroom talking #mycology #mushroommusic #fungi #nature
 Fungus The Real Network #mushrooms #fungus #mycelium #mycelium #fungus #mushrooms
Fungus The Real Network #mushrooms #fungus #mycelium #mycelium #fungus #mushrooms
 🍄 Fungi Computers: Mushrooms That Think Like Microchips! 💻
🍄 Fungi Computers: Mushrooms That Think Like Microchips! 💻
 How to shift Mycelium Growth for fungus Purification🔍#video #shorts
How to shift Mycelium Growth for fungus Purification🔍#video #shorts